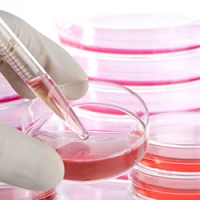

| |
|
|
Наш портал о-о-очень большой. Найдите то, зачем пришли!
|
|
|
9 мая 2020 года Пломбы из стволовых клеток Инновационный метод лечения зубов придумали в Индии. Местные врачи научились пломбировать зубные каналы с помощью стволовых клеток! Принцип технологии, получившей название SealBio, довольно прост — стимулировать рост стволовых клеток в основании зуба. Клетки начинают регенерацию, и в течение нескольких месяцев полностью запечатывают отверстие. Эта методика имеет множество преимуществ по сравнению с традиционными пломбами из цементирующих средств. Во-первых, такое лечение безболезненно. Во-вторых, дешево. Да, ведь пациенту не подсаживают чужие стволовые клетки (которые и правда стоят баснословных денег), а воздействуют на его собственные. В-третьих, исключается отторжение пломбы организмом. И, наконец, в-четвертых, для успешного пломбирования зуба достаточно одного приема у стоматолога. Сейчас в Индии завершаются клинические исследования SealBio. В рамках испытаний, стволовыми клетками залечили зубы у нескольких десятков пациентов. Никаких побочных эффектов или осложнений зарегистрировано не было. И это за четыре года наблюдений! Святослав Лидерман
Теги: Стволовые клетки | Ноу-хау
Другие материалы по этой теме:
Материал портала "PlasticReview" Стволовые клетки будут использовать для увеличения размеров женской груди статьи |
© Независимый портал о стоматологии «ВсёОстоматологии.ру» (2009 — 2025). Републикация текстовых и графических материалов сайта возможна только с письменного разрешения администрации. |














